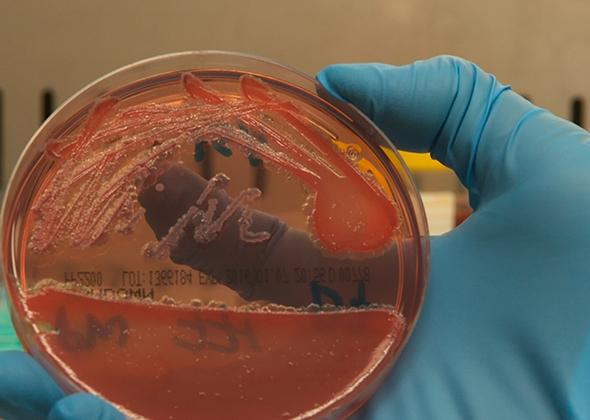

這是類鼻疽的故事,一個在東南亞和澳洲致命的熱帶病,隱伏在病人體內長達數週,數月,甚至幾十年,或是在48小時內就會讓病人死亡。
This is the story of Melioidosis, a life-threatening tropical disease in Southeast Asia and Australia which can remain dormant in a victim for weeks, months, even decades, or just kill within 48 hours.
MOD 258
殺戮者類鼻疽
Programmed To Kill: Meliodosis
2017/04/17 - 6:00am